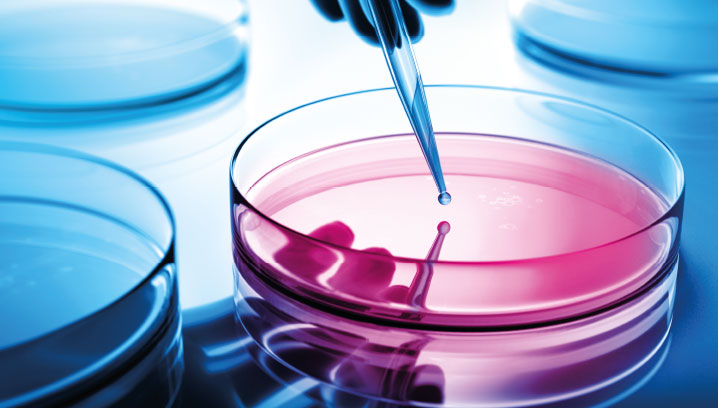

Cyber – das unterschätzte Risiko
In der Welt von heute können Cyber-Angriffe schwerwiegende Folgen haben. Die IT allein kann diese wachsende Herausforderung nicht meistern. Unternehmen sind gezwungen, ganzheitlich zu denken und zu handeln.
Hacker müssen nur eine kleine Schwachstelle im System finden – und die gibt es in nahezu jedem Unternehmen – oder einen Mitarbeiter täuschen. Schon haben sie Zugriff auf fremde Rechner, können Daten erbeuten und Netzwerke infizieren. Ist die IT erst einmal lahmgelegt, stehen schnell auch die Maschinen still. Die Schäden von Cyber-Angriffen sind enorm und können sogar zur existenziellen Bedrohung werden. Dabei sind es nicht zwingend Kriminelle, die die Schäden verursachen – viel häufiger sind es technische Probleme oder die eigenen Mitarbeiter.
Hier lesen Sie, wo Cyber-Risiken schlummern und wie Sie Ihr Unternehmen für die neuen Herausforderungen rüsten können. Mit der Cyber-Risk-Analyse oder einem Pen-Test erkennen Sie die Schwachstellen in Ihrem Unternehmen. Beim Versicherungsschutz können je nach Risikolage verschiedene Deckungen kombiniert werden. Unsere Experten aus Risiko- und Versicherungsmanagement beraten Sie gern dazu.
Beiträge zu Cyber-Risiken
Expertenfilm mit Hendrik Löffler
Jedes dritte deutsche Unternehmen wurde bereits Opfer von Hacker-Angriffen oder vergleichbaren Attacken auf die Unternehmens-IT. Cyber-Experte Hendrik Löffler erklärt, wie Sie Ihre IT schützen können. Klicken Sie einfach aus Bild!

Cyber-Risk-Analyse
In unserer digitalisierten Welt kann ein Cyber-Vorfall schnell ein ganzes Unternehmen lahm legen. Bei einem Workshop können individuelle Schwachstellen ermittelt werden. Was eine Cyber-Risk-Analyse leistet.
Mehr erfahren
Funk CyberSecure
Cyber-Risiken bedrohen die Wirtschaft. Funk bietet mit der Funk CyberSecure eine exklusive und individualisierbare Versicherungslösung. Wir geben einen Überblick über die enthaltenen Leistungen und versicherten Gefahren.
Mehr erfahren
Cyber-Schutz für Krankenhäuser
Mit Patientendaten lässt sich mehr Geld verdienen als mit Kreditkarteninformationen. Das ist nur einer der Gründe, warum Krankenhäuser und Kliniken ins Visier krimineller Hacker geraten.
Mehr erfahren
